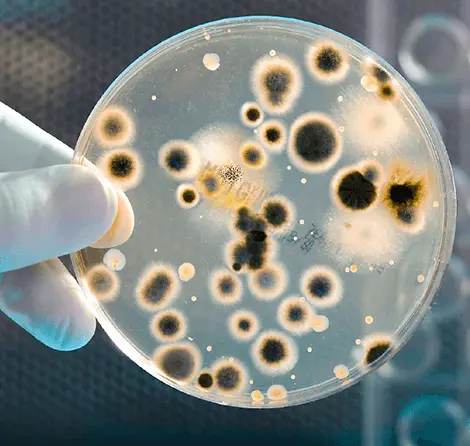
Entenda como funcionam bactericidas em tintas e revestimentos

Tempo de leitura: 6 minutosConheça as principais matérias-primas usadas na fabricação de tintas e entenda como cada insumo impacta qualidade e custo. Por que entender as matérias-primas usadas na fabricação de tintas faz toda a diferença? Quem trabalha com formulação de tintas sabe que…
Tempo de leitura: 6 minutosEntenda como o corretor de pH atua na formulação de tintas e garante estabilidade química. Soluções técnicas da Sumttex para a sua produção. Quem trabalha com formulação de tintas sabe que alguns parâmetros silenciosos têm peso enorme no resultado final….
Tempo de leitura: 5 minutosEntenda o que são espessantes acrílicos, como funcionam na fórmula e por que são essenciais no controle reológico de tintas e detergentes. Quando a viscosidade deixa de ser detalhe Quem já tentou aplicar uma tinta com viscosidade mal ajustada sabe…
Tempo de leitura: 5 minutosEntenda como os bactericidas em tintas protegem superfícies e garantem a integridade química de formulações modernas. Você já parou para analisar o campo de batalha microscópico que se torna uma lata de tinta após o envase? Para nós, formuladores, uma…
Tempo de leitura: 5 minutosEntenda como a dispersão de partículas otimiza o uso de pigmentos, reduz custos de matéria-prima e garante a eficiência na sua produção industrial. Muitas vezes, o custo elevado de uma formulação não está no preço por quilo da matéria-prima, mas…
Tempo de leitura: 4 minutosEntenda como a neutralização química e o uso de alcalinizantes de alta performance garantem a estabilidade de polímeros e evitam a perda de lotes industriais. Na rotina de uma planta industrial, a estabilidade de uma dispersão polimérica é o limite…
Tempo de leitura: 5 minutosAprenda a selecionar os agentes dispersantes ideais para tintas imobiliárias, garantindo estabilidade de pigmentos e alta cobertura com a Sumttex. A eficiência de uma tinta imobiliária é definida, em grande parte, pelo que acontece na escala microscópica durante a moagem….
Tempo de leitura: 5 minutosDescubra como o coalescente na formulação de tintas à base d’água melhora a formação de película, durabilidade e sustentabilidade em P&D de revestimentos. As tintas à base d’água ganharam protagonismo em formulações industriais e decorativas graças à menor emissão de…
Tempo de leitura: 5 minutosDescubra como os algicidas da Sumttex garantem proteção eficaz contra algas em diferentes aplicações industriais e ambientais. Os algicidas são produtos químicos desenvolvidos para eliminar e controlar o crescimento de algas em ambientes aquáticos e superfícies expostas à umidade. Sua…
Tempo de leitura: 4 minutosDescubra como a Sumttex se tornou referência nacional na fabricação e fornecimento de insumos para tintas com qualidade, inovação e suporte técnico especializado. A indústria de tintas exige mais do que apenas cor. Exige desempenho, durabilidade, custo-benefício e, acima de…